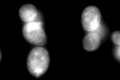

View description
Protein of unknown function containing a rhodanese-like domain; localized to the mitochondrial outer membrane
Localization:
Intensity:
Fold change:
Significance:
-
C’ GFP library in SD

ER143.84 -
N' NOP1pr-GFP in SD

N/A0 -
N' TEF2pr-mCherry in SD

N/A0 -
N' NATIVEpr-GFP in SD

N/A0 -
N' TEF2pr-VC and Cyto-VN in SD

N/A0 -
C’ GFP library in SD+DTT
ER275.851.91Yes -
C’ GFP library in SD+H2O2

ER120.860.84No -
C’ GFP library in Starvation Media

ER179.531.24No -
C’ GFP library on the background of Pup2-DaMP

ER -
C’ GFP library on the background of CCT mutant

ER134.2740.933425No
